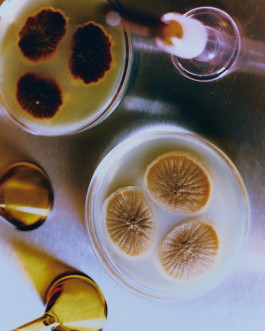

Ines Bressand AKAMAE bags
with Celia Moutawahid

Vuitton beauty special for Wall Street Journal
Set design: Daphné Davoise



Prada special for Wall Street Journal
Set Design: Daphné Davoise














Behind The Quiet Walls for Coeur magazine
Stylist: Marie Higushi





















Avsten SS25
AD Jessica Pichet
Styling Marie-Therese Haustein












Enji sonor library project for Squama records with Alyssia Lou











Duel magazine w/ Daphné Davoise & Céline Laviolette








REUNI







M Le Monde
Fetiches et Variation with Margot Thiry


Merci Paris







Merci Paris








At the glassblowers with Marie & Alexandre




Lale @faces1000




D La Repubblica with Giulia Querenghi






MOMEJ
DA : Margaux Vidrequin

MOLD magazine




Dockers


Monoprix, 2024



Acid magazine






TABLE Lipari campaign 2024



T le temps special Design










Shoeshoe Paris
AD Jessica Pichet
Styling Fanny Stranders




















Stephane Ashpool work in progress for le 19M














Martes vases, with Margot Thiry









Le Tanneur SS24




Monoprix, 2024
Set design: Aurore Sfez







ODDA magazine with Giulia Querenghi


Berries by Marie & Alexandre


Marina for COMBO magazine



Le Tanneur - christmas 23 campaign
AD by Margaux Vidrequin







Le Tanneur - christmas 23 campaign
AD by Margaux Vidrequin





Seven soap london

Seven soaps used archive





UNPOLISHED magazine

Icicle x semaine




ELLE déco
Set design: Aurore Sfez



Honey,
Style by Flora Mc Alpine




Nyandeng, 2023



Recherches avec Jeanne Tresvaux Du Fraval et Jessica Pichet








How to make a shoeshoe
AD Jessica pichet






For Reco Paris - Set Design by Nicolas Mur













VEJA campaign, 2023







Paul Andrew for FT weekend, 2023



Valentin, 2023



MA/RE collection






For SSIMONA





Rescha Paris











Anne Lise Michelson Jewelry
D.A: Clarice Fensterseifer
Set design: Lise Dupont













Itinérances méditérannée
With Marine Armandin








Orris Editorial
Set Design: Lara Romeo Esteller









Tedy Eiley collection



Beliflor, 2022
Set Design : Lise Dupont
DA : Lola Guisado








Lucia for Jasmine vintage








Special AZUR with Maud Dupuy




Personal still life project - Fragrances
Set design : Lise Dupont + Océane Algaron









Personal editorial with Marit Van Heumen bags






Personal project with Alice Rabot










Editorial for Nicotine Magazine
Still life with Marine Armandin









Fin de repas
Personal still life project with Océane Algaron & Lise Dupont




Personal still life project with Argot Studio
















Girls of Hyderabad
A project about women in India, with the artist Tiffany Bouelle




Personal editorial - styling by Mathilde Goulomes


Personal editorial - styling by Céline Laviolette




Personal - still life with Victor Tual





M Le Monde - Fragments de France
The 13th arrondissement of Paris





Roller Derby girls for Marie Claire FR









Editorial for Take Care Magazine #4 - Collages by Victor Tual



Personal project with Elodie Lou



Portraits of Hugo, 2020



Dior men accessories ss21
Set Design by Marine Armandin





Absolution cosmetics
Set Design by Lise Dupont





jагода - personal edito styling by Mathilde Goulomes





Salomeja Jacquet collection




Ja Mun Mai collection













Queen of pomegranate - Editorial for Television Magazine
Styling by Célia Moutawahid
Set design by Marine Armandin

Portrait of Kevin De Bruyne for L'Equipe Mag




Personal edito styling by Maud Dupuy




This is Badlands #3 - Marina Damjanovic



Ja Mun Mai collection






Ten days un India - Personal



House of twins
Styled by Maud Dupuy

Safdie brothers for Les Inrocks

Swimming pool during covid - L'Equipe Mag


America, 2014

Laure Calamy for Les Inrocks